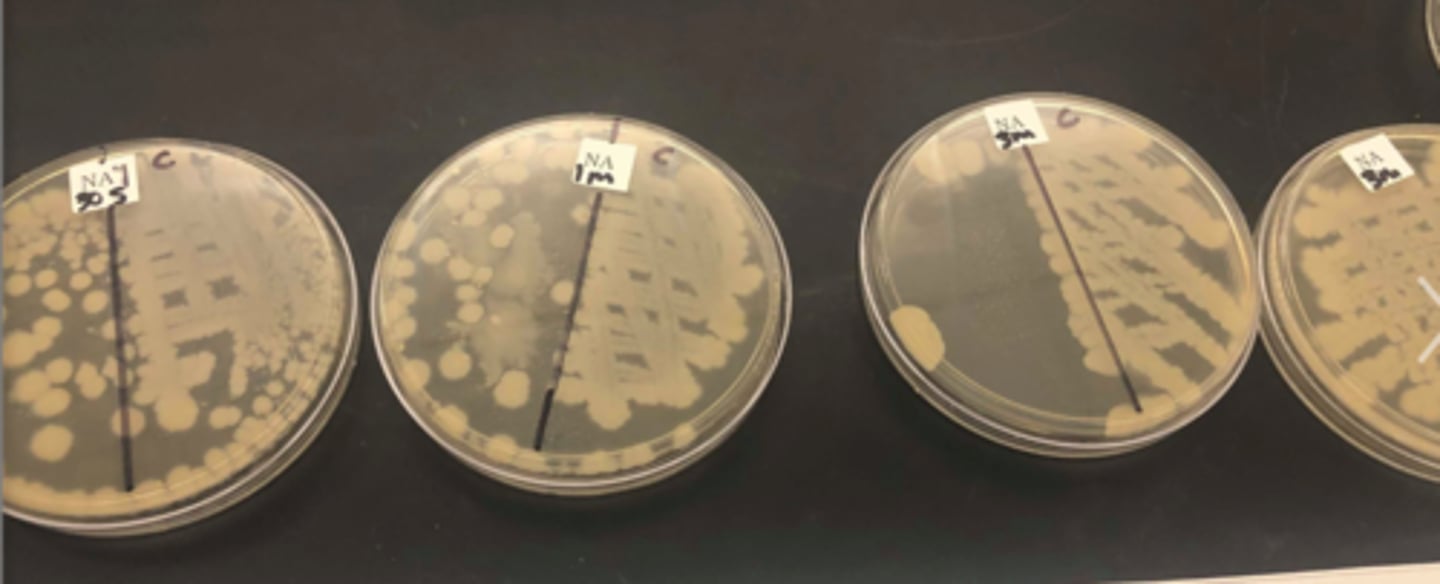
<p>In the DUV LED plate study, the half of the agar plate covered with aluminum foil serves as a...</p>

LSU BIOL 2051 Final Exam- Dr. Nita
1/470
There's no tags or description
Looks like no tags are added yet.
Name | Mastery | Learn | Test | Matching | Spaced |
|---|
No study sessions yet.
471 Terms
its extraordinary ability to repair DNA, particularly double-strand breaks
Deinococcus radiodurans is famous for surviving extreme doses of gamma radiation. Its survival is primarily attributed to...
adapt, survive, or perish
A "gene-environment interaction" as mentioned in Handout-8, describes how the interplay between a bacterium's genetic makeup and its surrounding environment determines its growth outcome.
Non-optimal conditions imply that the environment is not ideal for the bacteria's survival. This can lead to several possible consequences, such as _________, ___________ and ___________.
resynthesis of the strand to fill the gap
A bacterial mutant with a non-functional *DNA polymerase* would be unable to complete which step of NER?
Psychrophile
A bacterium is isolated from a 4°C environment. Its enzymes are found to denature rapidly at 30°C. This organism is a:
High temperature
A bacterium with a defective RpoH sigma factor would likely be most vulnerable to which specific environmental stressor?
Gamma radiation, because it is ionizing and highly penetrating
A food-processing plant wants to sterilize pre-packaged, opaque plastic syringes.
Which sterilization method would be most effective? Why?
UV light creates dimers, while gamma radiation creates strand breaks and reactive oxygen species
A key difference between the DNA damage caused by UV light and the damage caused by gamma radiation is that...
low penetration, making it ineffective in shadows or on porous materials
A major limitation of UV surface disinfection, as noted in the materials, is its...
synthesis of Heat Shock Proteins (HSPs) like Hsp70 to refold denatured proteins
A mesophilic E. coli culture is abruptly shifted from 37°C to 45°C, and growth is slowed.
Which stress response is most likely to be activated to manage protein damage?
activation of cold shock proteins (CSPs) and production of cryoprotectants
A mesophilic bacterium is shifted to a 15°C environment.
Which two distinct mechanisms are mentioned as part of the "cold shock response"?
It has a standard activation energy and denatures at extreme high or low temperatures
A mesophilic enzyme functions best at a moderate temperature because...
thermophile; proteins are rigid and have a high number of salt bridges
A microbe's membrane is found to be rich in saturated, straight-chain fatty acids and ether linkages.
What can be inferred about its optimal growth environment and protein structure?
0°C, 10°C, 37°C, and 60°C
A microbiologist is designing an experiment to determine if an unknown bacterium is a true psychrophile or a mesophile.
Based on the provided slides and lab manual (where we tested 0°C, 4°C, 37°C, 60°C, and 100°C), what is the most critical set of growth temperatures to test?
Psychrophile
A newly discovered bacterium possesses enzymes with high glycine content, a cell membrane rich in polyunsaturated fatty acids using ester linkages, and actively produces CSPs at 10°C. This organism is best classified as a:
extremely sensitive to UV light, as they cannot repair pyrimidine dimers effectively
A patient with the genetic disease xeroderma pigmentosum (XP) has a defective NER system. This patient would be...
the fever is approaching the bacteria's maximum growth temperature, which can denature its mesophilic enzymes
A pre-med student is studying a Staphylococcus aureus (a mesophile) infection. Why is the patient's high fever (e.g., 40°C / 104°F) a problem for this bacterium?
Ether-linked membranes, high percentage of saturated fatty acids, and enzymes with a high activation energy
A research team discovers a novel archaean in a 95°C hydrothermal vent. Which combination of molecular adaptations would they most expect to find?

Culture B will show a higher survival rate due to photoreactivation
A researcher exposes two identical cultures of E. coli to a sterilizing dose of UV light. Culture A is incubated in a dark room. Culture B is incubated under a bright visible-light lamp. What is the predicted outcome?
Butter or wax-like (high saturated fats, solid at room temp), promoting rigidity
A student analyzing the membrane of a thermophile would expect to find a high concentration of lipids that are analogous to...

Psychrophiles use fewer salt bridges to maintain flexibility, and the cold shock response involves CSPs
A student incorrectly claims that psychrophiles use "an increased number of salt bridges to protect against cold."
Why is this statement false, according to the provided material?
Psychrotolerant
A student isolates a bacterium that grows optimally at 37°C, but also shows significant growth when left in a 4°C refrigerator for a week.
Based on the growth curve graph, this organism is best classified as a _________:

Mesophile
A student observes a growth curve for an unknown organism. Growth begins at 20°C, peaks at 40°C, and stops at 50°C.
How should this organism be classified?

more stable ether linkages and, in some cases, tetraether lipid monolayers
A thermophilic archaeon membrane is uniquely stable due to the presence of:

E. coli (Gram-negative) is more sensitive to DUV radiation than Listeria innocua (Gram-positive).
Analysis of the DUV LED plate study for the 30s and 60s exposure times suggests that...

Its ester-linked membrane lipids and proteins would denature, leading to cell death
Based on the provided information, what would happen if a mesophilic bacteria were placed in a 90°C environment?
an excision and replacement; a direct reversal
Comparing repair mechanisms, NER is considered ________ while photoreactivation is ________.
forming more stable oligomers with additional subunits
How do thermophilic proteins increase structural stability at the quaternary level of proteins?
incorporating unsaturated and branched-chain fatty acids, which introduce kinks and prevent solidification
How does the cell membrane of a psychrophile, like the "olive oil" analogy, maintain its function in the cold?

The bacterium would be highly sensitive to UV, as it could not repair pyrimidine dimers by either major pathway
If a bacterium lacks BOTH photolyase and the nuclease enzyme required for NER, what would be the consequence of exposure to UV light?
The organism's proteins would lose stability and denature at its optimal growth temperature
If a DNA mutation occurred that prevented a thermophile from forming sufficient salt bridges, what would be the most likely consequence?
The membrane will solidify, preventing transport and leading to cell death
If a researcher experimentally "saturates" the membrane lipids fats of a psychrophile (i.e., removes unsaturated fats by removing the C=C cis-double bonds to make it look like saturated fats C-C seen in butter), what will happen when the cell is placed at its optimal cold temperature?
positive control, to confirm the bacteria are viable and that DUV light is the variable causing cell death
In the DUV LED plate study, the half of the agar plate covered with aluminum foil serves as a...
Hydrophobic/non-polar and polar/hydrophilic/charged
Most thermophilic proteins are enriched with core of non-polar amino acids - Isoleucine (I), Valine (V), Tryptophan (W), Leucine (L) that are _____________ nature.
Thermophilic proteins also contain some surface amino acids that are basic (Arginine and Lysine) and acidic (Glutamic acid and Aspartic acid) that have a ____________ property.
What two classes of amino acids are represented by this list respectively?
Bacillus cereus
The "adapt, survive or perish" concept can be applied to radiation exposure. Which organism survives gamma radiation by forming a dormant structure?
the physical impact of the gamma ray breaking the DNA backbone
The "direct damage" from gamma radiation refers to...

The ionization of water molecules, creating free radicals
The "indirect damage" pathway of gamma radiation involves which initial event?

the formation of a cyclobutane ring (dimer)
The "saturation of the double bonds between carbons 5 and 6" of adjacent pyrimidines is the chemical definition of...

ensures the cell only expends energy to metabolize lactose when it is environmentally present
The lac operon, as described in the materials, is a key example of "gene-environment interaction" because it...

a plateau where the rate of cell growth equals the rate of cell death, often due to nutrient limitation
The bacterial growth curve at a "Stationary" phase. This phase is characterized by...

The rigidity (butter) of saturated fats vs. the fluidity (olive oil) of unsaturated fats
The butter and olive oil images serve as an analogy for:

the stability and DNA protection of endospores against stresses like gamma radiation
The components Ca-DPA (Calcium dipicolinate) and SASPs (Small Acid-Soluble Spore Proteins) are crucial for...

Photolyase
The enzyme responsible for photoreactivation is called...
blocks the progression of both DNA polymerase and RNA polymerase
The formation of pyrimidine dimers is a critical mutagenic event because it directly...

Glycine is the most flexible amino acid; reducing it increases the protein's structural rigidity
thermophilic proteins have reduced glycine.
What is the functional reasoning for this?
To promote stronger hydrophobic interactions in the protein's core, increasing its stability
thermophilic proteins have "an enrichment of hydrophobic residues (I, V, Y, W, L) and (R, E)."
What is the likely purpose of this in addition to salt bridges?
A nuclease cleaving the phosphodiester backbone on both the 3' and 5' sides of the lesion
The mechanism of Nucleotide-Excision Repair (NER) is initiated by what enzymatic action?

DNA
The milk UV case study lists a wide variety of pathogens (Listeria, E. coli, Staphylococcus). The universal target of the UV light in all these different bacteria is their...
Does UV light denature the beneficial immune proteins in colostrum while killing pathogens?
The milk UV treatment study also measures IgG (immunoglobulant) concentration. What is the most critical clinical question this part of the study addresses?

regulate gene expression to "adapt, survive or perish" in response to environmental cues
The overall process of gene-environment interaction allows a bacterium to...
Photoreactivation, which uses visible light to reverse the dimers
The question "What if soon after UV treatment the bacteria can repair T-T dimers?"...directly refers to which specific repair mechanism?

the extracellular polymeric substance (EPS) of the biofilm can absorb or scatter UV photons
The UV disinfection of water can be compromised by the presence of biofilms because...
The milk must be shielded from all sources of visible light
To prevent photoreactivation from compromising the disinfection in the milk case study, what operational factor must be controlled after the UV treatment?
Log phase, because DNA replication is active and essential for division
UV light disinfection is most effective against bacteria in which phase of the growth curve?

activating CSPs to manage transcription and translation and producing cryoprotectants to prevent ice crystal formation
What adaptations in the "cold shock response" seen in a bacteria growing at 5°C, best describes how psychrophiles can survive this environment?
The environmental stress is so far outside the optimal range that the organism's adaptive responses (like HSPs/CSPs) are overwhelmed
What does the "perish" outcome of a gene-environment interaction imply?
An electrostatic interaction between opposite charges, such as aspartate (D) and arginine (R)
What is the defined function of a "salt bridge" in the context of thermophilic proteins?
It significantly reduces enzyme activity at moderate temperatures because thermophiles need higher Ea / thermal boost to work efficiently
What is the direct kinetic consequence of the rigid protein structure favored by thermophiles?
To prevent the enzyme's active site from denaturing and losing its shape at high temperatures
What is the fundamental purpose of a thermophile's rigid enzyme structure, despite it resulting in a high Ea?
A psychrophile's optimal temperature is below 15°C, while a psychrotolerant's optimum is in the mesophilic range (e.g., 25°C) but it can still grow at 0°C
What is the key difference between a psychrophile and a psychrotolerant organism, based on the graph?

A higher number of glycine residues and a lower ratio of charged/aromatic residues
What is the key structural difference in the proteins (not enzymes) of a psychrophile compared to a *mesophile?
To refold denatured proteins and prevent aggregation at high temperatures
What is the primary function of Heat Shock Proteins (HSPs) like Hsp70?
To regulate gene expression for survival during the stationary phase or under general stress
What is the primary function of the RpoS sigma factor in bacteria, based on its implied role in gene-environment interaction?
Their flexible structure gives them a low Ea for cold activity, but makes them highly susceptible to denaturation at moderate temperatures
What is the primary thermodynamic trade-off for enzymes found in psychrophiles?
To prevent ice crystal formation, which can lyse the cell
What is the specific function of cryoprotectants as part of the cold shock response?
To unwind and remove the oligonucleotide containing the damaged bases
What is the specific function of the *helicase* in the NER pathway?

A cyclobutane ring between adjacent pyrimidines on the same DNA strand
What is the specific molecular lesion formed by UV radiation that is depicted in the slides?

Aspartate (D) or Glutamate (E) with Lysine (K) or Arginine (R)
What specific amino acids are identified as forming the oppositely charged pairs in a salt bridge that occurs between functional groups of _________________ which pairs with _____________ ?
flexible structure, low Ea, and high glycine content
Which combination of features allows a psychrophilic enzyme to function efficiently in the cold?
DNA ligase
Which enzyme is responsible for sealing the final phosphodiester bond to complete the NER process?
a lower ratio of charged and aromatic residues to increase flexibility
What describes a key adaptation of a psychrophilic protein?
visible light
What environmental factor is used as the basis for the photoreactivation repair mechanism?
RpoH is a sigma factor controlling a global stress response; the lac repressor is a transcription factor for a specific metabolic pathway
What is a key difference between RpoH and the lac repressor?
humans
What organism lacks the photoreactivation mechanism, making it entirely dependent on other pathways like NER for pyrimidine dimer repair?
Bacillus cereus
what organism would likely be more resistant to the UV treatment if it were in its endospore form?
Nuclease, Helicase, DNA Polymerase, Ligase
What set of enzymes is required for Nucleotide-Excision Repair?
Thermophiles reduce glycine to increase rigidity; psychrophiles increase glycine to increase flexibility
What statement accurately contrasts the protein adaptations of a thermophile and a psychrophile?
Photoreactivation requires visible light; NER is light-independent and requires ATP
What statement accurately contrasts the energy sources for the two main dimer repair pathways?
It uses a balance of adaptations, such as a mix of saturated/unsaturated fats and standard enzyme kinetics, to thrive in moderate conditions
What best describes the "standard" nature of a mesophile?
Bacillus and Clostridium
Which two bacterial genera are noted for their ability to form endospores to persist in nature?
Ether bonds are chemically more resistant to hydrolysis (breaking apart) at high temperatures
Why are ether linkages (common in thermophilic archaea) more stable than the ester linkages used by mesophiles and psychrophiles?
It survives radiation by actively repairing massive DNA damage, not by entering a dormant state
Why is Deinococcus radiodurans not considered an endospore-former, despite its extreme resistance?
To form a significantly higher number of internal and surface salt bridges, which increases thermostability
Why is a thermophilic protein described as having an "enrichment of charged residues (Aspartic acid [D], Glutamic acid [E], Lysine [K], Arginine [R])"?
UV light has low penetration and cannot pass through the can, and C. botulinum forms highly resistant endospores.
Why is UV radiation, as used in the milk study, not an effective sterilization method for a sealed can of food suspected of contamination with Clostridium botulinum?
The moderate temperature is insufficient to overcome its high activation energy
Why would a thermophilic enzyme have significantly reduced activity at moderate temperatures (e.g., 37°C)?
Arginine Deiminase System (ADS)
For bacterial acid resistance, which mechanism is employed by Listeria monocytogenes but NOT by Salmonella enterica?
It generates polluting acidic mine drainage, but it also colonizes barren landscapes, driving ecological succession
Acidithiobacillus ferrooxidans has a dual ecological role. What is it?
Synthesizing or importing compatible solutes (osmolytes) like glycine betaine, trehalose, or proline
A "halotolerant" organism, like Staphylococcus aureus and S. epidermidis, is placed in a 7% NaCl solution, which is far above its optimal 1% NaCl. It survives. Which mechanism is it most likely to use for long-term survival?
Upregulation of heat shock proteins (HSPs) like DnaK, GroEL, or ClpB
A Campylobacter jejuni cell is exposed to acid stress, causing some of its proteins to denature. Which indirect defense mechanism is specifically involved in refolding and repairing these proteins?
F0F1 ATPase
A Salmonella enterica mutant is unable to hydrolyze ATP. Which acid resistance system would be directly inactivated?
The pump will be non-functional, as its operation is coupled with ATP hydrolysis
A bacterial cell has a functional F1F0 ATPase pump but is in a cellular environment with no ATP. How will this affect its "direct defense" against acid?
The L. monocytogenes glutamate decarboxylase system; both consume H+ during amino acid conversion
A bacterium is found to use a lysine decarboxylase (CadA/CadB) system to survive acid. This mechanism is most similar to which other system? How?
It could directly neutralize H+ using urea hydrolyzed to ammonia and also be repaired/refolded by molecular chaperones to avoid being denatured by the acid
A bacterium is genetically engineered to have both the H. pylori Urease system and the C. jejuni ClpB chaperone.
If this cell is exposed to severe acid stress, what two distinct defense capabilities would it possess?
Altering cellular metabolism—slowing down transcription and translation
A bacterium is noted to slow its production of ribosomal proteins during acid shock. This is an example of which indirect defense strategy?
hypertonic
A bacterium is placed in a solution and immediately undergoes plasmolysis. The solution was:

Respiratory proton pumps
A bacterium uses the Proton Motive Force (PMF). Which mechanism generates or maintains the PMF by actively pumping protons OUT of the cell using energy from the electron transport chain?

Urea will be unable to enter the bacterial cytoplasm
A drug is designed to perfectly inhibit the UreI channel in H. pylori. What is the direct and immediate consequence of this inhibition in an acidic environment?

Extreme halophile
A microbiologist discovers a bacterium that grows optimally at 20% NaCl concentration and does not grow at all below 10% NaCl. This organism is best classified as a(n):
It will be unable to survive long-term osmotic stress, as it cannot produce this key compatible solute from the precursor
A mutant E. coli lacks the enzymes to convert choline to glycine betaine. How will this cell most likely compare to a wild-type cell when placed in a high-salinity environment containing choline?
Urea will flood the cytoplasm but cannot be hydrolyzed, leading to osmotic stress as the periplasm and cytoplasm acidify
A mutant H. pylori has a functional UreI channel but a non-functional urease enzyme. What is the most likely outcome for this bacterium in an acidic (pH < 6.5) stomach?
Arginine Deiminase System (ADS)
A mutation in Listeria monocytogenes prevents it from producing ammonia (NH3). Which acid defense system is defective?